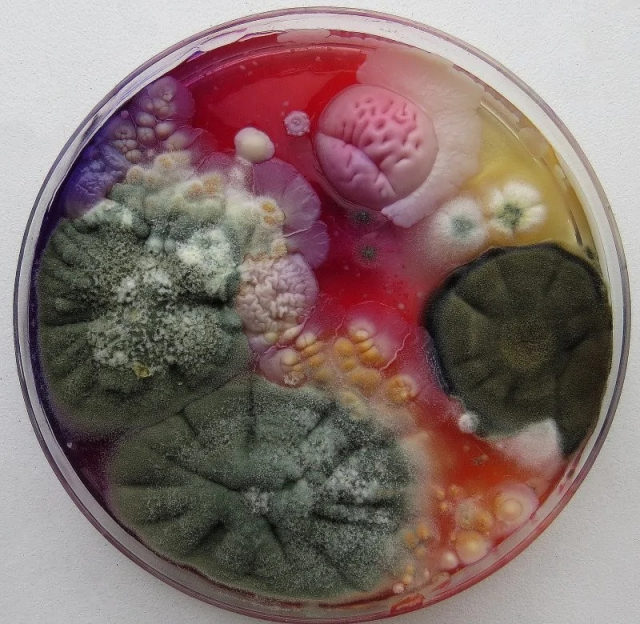

Повседневная жизнь со своими монотонностью и постоянством постепенно притупляет восприимчивость любого, даже самого впечатлительного человека. Однако важно помнить, насколько красив и интересен окружающий мир. Предлагаем вашему вниманию подборку уникальных фотографий обычных вещей и явлений, позволяющую взглянуть на них совершенно иначе.
Стержень шариковой ручки

Таким образом в Нидерландах делают кирпичные дороги

Обзор театра из-за сцены

Так выглядит нижняя часть листа водяной лилии

Обычная спичечная головка

Застёжка-молния, которой мы пользуемся десятки раз в день

Внутреннее строение черепахи

Дыхало кита, представляющее собой видоизменённые и смещённые на макушку носовые отверстия (ноздри)

Внутренний мир жемчужин

Игла и нить

Установка линий электропередач

Солянка сорная - перекати-поле перед тем, как оторваться от земли и отправиться в бесконечное путешествие

Капельки пота на кончике человеческого пальца

Так выглядит внутренняя часть бильярдного стола

Замерзающий мыльный пузырь

Трёхцветная зубная паста в тюбике

Внутренняя часть зажигалки Zippo

Цветок лаванды

Плесень в чашке Петри
Вид Антарктиды из космоса







